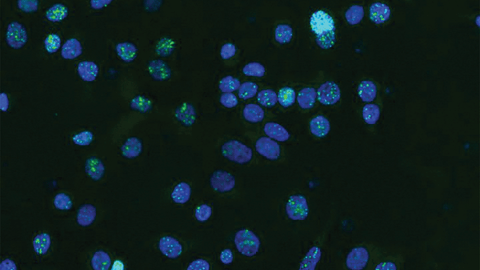

Explore by decade.
2024

New class of cancer mutations discovered in so-called ‘junk’ DNA
Using artificial intelligence, Garvan Institute researchers have found potential cancer drivers hidden in so-called ‘junk’ regions of DNA, opening up possibilities for a new approach to diagnosis and treatment.

International partnership to map 50 million human cells and uncover genetic fingerprints of disease
The Garvan Institute and Illumina, a global genomics and human health company, are partnering on the $27 million TenK10K project to help transform the treatment of complex diseases, starting with autoimmune diseases.
2023

Unique diversity of Indigenous Australians revealed by next-generation genomics
New research provides the most comprehensive picture to date of the genomic diversity within and between First Nations communities across Australia.

Drug that targets scar-like tissue in tumours shows promise for aggressive pancreatic cancer
Early laboratory results in mice show the drug PXS-5505 increases survival when combined with chemotherapy in the treatment of pancreatic ductal adenocarcinomas.
2022

Single test for over 50 genetic diseases will cut diagnosis from decades to days
Revolutionising diagnostic practices for over 50 genetic diseases, researchers showed that Nanopore Sequencing – technology developed by Garvan scientists to scan a patient’s genome – can accurately diagnose neurological and neuromuscular genetic diseases quickly and cost-effectively. These diseases have historically been challenging to diagnose, often leaving patients without a diagnosis for decades. Garvan’s groundbreaking technology can accurately diagnose these diseases within days, allowing patients faster to access the healthcare they require.

An immune ‘fingerprint’ reveals path for better treatment of autoimmune diseases
In the largest study of its kind to date, researchers linked disease-causing genes to specific types of immune cells by analysing over one million cells from 1000 people. This allowed them to identify a genetic fingerprint linking genetic markers to diseases such as multiple sclerosis, rheumatoid arthritis, lupus, type 1 diabetes, spondylitis, inflammatory bowel disease and Crohn’s disease. The discovery may help individuals find tailored treatments that work for them based on their genetic fingerprints and guide the development of new drugs.

Collagen a key player in breast cancer metastasis
Researchers found that the levels of collagen XII in a tumour’s microenvironment alter tumour properties and make it more aggressive. In a study focused on breast cancer, researchers found that high levels of collagen XII were associated with increased metastasis and poorer survival rate. This research suggests that levels of collagen XII in tumour biopsies could potentially be used to identify patients with more aggressive types of breast cancer.

ACRF INCITe Centre for world-class cancer imaging launches at the Garvan Institute
On 30 June, the ACRF Intravital Imagine of Niches for Cancer Immune Therapy (INCITe) Centre was officially launched. This centre houses two Australian-designed, world-leading microscopes that allow researchers to observe the interactions between cancer cells and the immune system in real time, providing greater insight into how drug-resistant, dormant cancer cells develop and function.

Pancreatic cancer clinical trial to test new approach to treatment
In collaboration with Amplia Therapeutics, researchers launched a new clinical trial to explore findings by Garvan researchers that suggest a new drug called AMP945 can help break down the defences of pancreatic tumours in patients with pancreatic ductal adenocarcinoma. This aggressive form of pancreatic cancer is one of the most lethal cancers worldwide, with extremely low survival rates.

New epigenetic markers for prostate cancer discovered
Using tumour samples from 185 patients collected over 20 years, scientists discovered a new biomarker for a lethal form of prostate cancer – a gene called CACNA2D4 which is involved with calcium channel regulation. This biomarker could potentially be used to identify patients who may benefit from receiving aggressive treatments earlier.

World-first gene therapy clinical trial for type 1 diabetes to proceed
A world-first clinical trial developed by Garvan researchers was launched to test how genetically engineered cells might restore insulin function and reduce the need for immunosuppression in patients with type 1 diabetes. In the trial, pancreatic islet cell that have been genetically engineered to prevent the immune system from damaging them, are transplanted into the livers of participating patients. Islet cells are responsible for sensing the concentration of sugar in the blood and producing the hormone insulin. If successful, this new therapy will eliminate the need for patients to take immunosuppressants, while also reducing a patient’s reliance on insulin injections.

Clinical trial will test drug treatment for prevention of dementia
Following a six-year study, Garvan researchers launched a clinical trial to test the use of metformin – a drug commonly used to treat diabetes and other metabolic disorders – in slowing cognitive decline to prevent dementia. The three-year intervention study will examine the effects of metformin on cognition, brain anatomy, vascular health and early signs of dementia.

DNA barcoding reveals cancer cells’ ability to evade the immune system
By using DNA barcodes to track cancer over time, researchers showed that some cancer cells deploy parallel mechanisms to evade the immune system’s defences and to resist immunotherapy. For instance, researchers found that breast cancer cells can suppress the action of killer T-cells and hinder the immune system’s ability to flag tumour cells for destruction. The mechanisms used by cancer cells could be used for potential targets for therapies that stop tumorous cells from adapting and spreading.
2021

Researchers reveal a strategy for next-generation COVID-19 vaccines
Garvan-led researchers outline a strategy to generate future-proofed COVID-19 vaccines that can resist emergent new viral strains.

Pancreatic cancer ‘priming’ may make chemotherapy more effective
In preclinical models, a team at the Garvan Institute of Medical Research could enhance the tumours’ response to chemotherapy by reducing the stiffness and density of the connective tissue known as the stroma, and reduce cancer spread by up to 50%.

Sydney researchers develop rapid genomics strategy to trace coronavirus
A team of leading Sydney researchers pioneered the use of a fast genomic sequencing technology to help determine the source of hard-to-trace coronavirus cases.

New type of bone cell could reveal targets for osteoporosis treatment
Using intravital imaging of living bone tissue, researchers identified a new type of bone cell – osteomorphs – which fuse together to form osteoclasts, which help break down and recycle old parts of the skeleton. The study identified that the osteomorphs have a unique genomic profile separate to osteoclasts, revealing promising and as yet unexplored targets for therapy for a number of skeletal diseases.

How antibodies make the switch to better immunity
Researchers uncovered that antibodies that are specialised to different immune ‘disposal systems’ become the dominant form in the bloodstream by being selected in germinal centres, like the lymph nodes, spleen and tonsils. This process is critical in the immune system’s ability to destroy pathogens and a key objective for the development of effective vaccines.

A universal vaccine that could bring an end to the COVID-19 pandemic is now in development at Garvan
A Garvan-led study revealed a guide to developing COVID-19 vaccines that both prevent the coronavirus from infecting human cells and that are more resistant to evolving viral strains. This involves targeting regions of the SARS-CoV-2 viral surface that are unlikely to mutate.
2020

Revealed: how cancer develops resistance to treatment
Researchers uncovered a fundamental survival strategy that cancer cells use to develop drug resistance – stress-induced mutagenesis. In this strategy, cancer cells shuffle their genome when exposed to targeted therapies – a common treatment for many forms of cancer – generating high numbers of errors that lead to drug resistance. This is similar to the process bacteria use to develop antibiotic resistance. This suggests that combining conventional targeted cancer therapies with drugs that target DNA repair mechanisms may lead to improved outcomes for patients.

Treatment linked to slowed cognitive decline
A research study showed that individuals who use the medication metformin to treat type 2 diabetes also experience slower cognitive decline with lower dementia rates than those who do not. This provides new hope for reducing the risk of dementia by repurposing a cheap and safe medication.

Flexible targets help immune system make finely-tuned antibodies
In response to the COVID pandemic, researchers began developing genetically engineered antibodies designed to target the surface proteins of SARS-CoV-2, which the virus uses to infect human cells. These highly specific antibodies could provide immunity, both for treatment of COVID-19 and for prevention for at-risk individuals.
2019 - 2010

Psoriasis drug target offers potential for osteosarcoma
A study suggested that a common treatment for psoriasis could be repurposed to treat osteosarcoma – a rare but aggressive cancer that affects young people. Researchers showed that blocking the IL23 molecule in mice successfully shrank tumours. Drugs that block IL23 are already safely used to treat patients with psoriasis, suggesting that they could also be used to treat patients with osteosarcoma.

Discovery that the molecule osteoglycin – which is important in situations of changing energy balance, due to changes in weight – is blocked in obesity. This makes more glucose available to form bone, which then strengthens the skeleton, revealing how the brain, bone and bloodstream communicate with one another to coordinate weight changes and bones mass.

Genomics yields a new understanding of pancreatic cancer
A breakthrough study of over 450 pancreatic cancer genomes showed that pancreatic cancer can be divided into four distinct diseases, each of which many respond differently to therapies, meaning this study has implications for how clinicians assess and treat pancreatic cancer

Know Your Bones: new online bone health assessment tool launches
In collaboration with Osteoporosis Australia and as part of the Bone Alliance, Garvan co-launch the ‘Know Your Bones’ campaign, which made Garvan’s Fracture Risk Calculator available to the public for free use, signifying the translation of research into clinical practices

Discovered that osteoblasts – or bone-forming cells – need to be able to respond to the signalling molecule neuropeptide Y (NPY), to pass on messages to the pancreas to increase insulin production. This discovery sheds new light on the bone-pancreas ‘road map’, pointing to new pathways that regulate glucose homeostasis that may lead to new treatments for metabolic diseases.

Developed novel epigenetic sequencing technologies and bioinformatics tools to unravel layers of chemical change that affect the ways in which genes behave, and demonstrated which sections of the genome are commonly ‘activated’, or ‘switched on’, in prostate cancer. This work provides new diagnostic markers for prostate cancer and provides a new mechanism for cancer-specific gene activation.
Demonstrated that a molecule known as ‘hedgehog’ helps breast cancer cells survive by communicating their needs to the healthy cells that surround them. Hedgehog-blocking drugs (in trial for other cancers) offer a potential new therapy for breast cancer

Proved that inflammation in the brain prevents stem cell proliferation and neural repair, a finding that will have important therapeutic implications for Parkinson’s and Alzheimer’s disease

Identified a new group of immune cells (a subset of T cells) that for the first time directly link two autoimmune diseases – type 1 diabetes and Sjögren’s syndrome.

Demonstrated which sections of the genome are commonly ‘silenced’, or ‘switched off’, in prostate cancer. This work not only provides new diagnostic markers for prostate cancer, it suggests that all cancers show similarly widespread and specific silencing
2009 - 2000

Demonstrated that a tiny genetic irregularity in the gene encoding for the growth factor IL-21 greatly boosts its expression, leading to the development of type 1 diabetes in mice. The absence of the irregularity, on the other hand, keeps IL-21 at normal levels and prevents development of the disease

Reported findings of initial clinical studies with a novel treatment that reduces bone breakdown, and which has major potential in osteoporosis treatment

Cancer researchers found that by ‘switching off’ the Id1 gene, produced by the most aggressive forms of breast cancer, it is possible to induce a state of ‘senescence’, or permanent sleep, within a tumour, preventing it from growing or spreading

Garvan immunologists discovered that the complex process of producing potent antibodies to fight infection hinges on a single molecule known as IL-21, a growth factor, without which it cannot function. This finding suggests ways to strengthen the body’s natural defences

Found that macrophage inhibitory cytokine-1 (MIC-1), a molecule released in high quantities by tumours, acts on the hypothalamus of the brain to inhibit appetite and reduce body weight, providing new hope for the treatment of cancer-related anorexia and obesity

Determined that cancer cell DNA with altered methylation patterns can be found in the blood of women with ovarian cancer, paving the way for a new diagnostic approach

Demonstrated the unique role of a novel PKC enzyme isoform in insulin resistance. Deletion of this gene results in protection from insulin resistance, making PKC a potential target for drug discovery

Identification of a genetic variation that contributes to the risk of developing Parkinson’s disease.

Using microarray analysis of more than 46,000 unique gene sequences in more than 100 prostate cancer samples, researchers identified several genes than can predict prostate cancer outcome better than the standard PSA test

The completion of the first draft of the human genome sequence was announced
1999 - 1990

Reported the increased risk of premature death after all types of osteoporotic fractures

Showed that accumulation of ceramides (fat derived molecules) in muscle cells reduces the effectiveness of insulin

Established the role of key oncogene c-myc in breast cancer

New Garvan building officially opened

Discovered the importance of the enzyme Protein Kinase C in the development of insulin resistance

Revealed a major benefit of transdermal versus oral oestrogen – the reduction of fat accumulation in menopausal women

Discovered the role of cell cycle genes – proteins called cyclins – in breast cancer

Demonstrated that the variation in the vitamin D receptor gene contributes to differences in bone density and susceptibility for osteoporosis

Cloned the neuropeptide Y (NPY) receptor, leading to greater understanding of how this potent brain molecule controls important functions such as the immune system and appetite

Cloned human galanin, a brain chemical that regulates appetite, anxiety and depression
1989 - 1980

Established the Dubbo Osteoporosis Epidemiology Study

Identified fat accumulation in muscle and liver cells as a major cause of defective insulin action, leading to diabetes

Demonstrated the strong heritability of bone density and therefore osteoporosis risk

Demonstrated the effect of tamoxifen on breast cancer growth

Produced Australia’s first genetically engineered human therapeutic growth hormone

Successfully applied artificial intelligence techniques to laboratory-based clinical diagnosis

Used novel techniques (clamp + tracers) to reveal differential effects of insulin among its target tissues, such as muscle, heart, liver and fat

Discovered a connection between brain noradrenalin metabolism (a stress response) and blood glucose levels

Discovered that taking fish oil helps combat insulin resistance

Garvan Research Foundation established on 1 January, to support Garvan’s research activities
1979 - 1960

Dr Margaret Stuart (Assistant Director) along with Dr Anne Underwood (CSIRO) commenced a monoclonal antibody project, which carried out cell fusions for hybridoma production and ran until 1985

Recognised for the first time that patients with diabetes may be unable to produce hormones to prevent low blood glucose levels

Developed one of the first experimental versions of an ‘artificial pancreas’

Identified the role of brain serotonin and melatonin in regulating pituitary hormone secretion

Developed a life-changing insulin infusion technique to treat ketoacidosis – a complication of diabetes

Garvan developed an Australia-first ‘radioimmunoassay’ technique to measure growth hormone in people

Garvan Institute officially opened on 17 February

